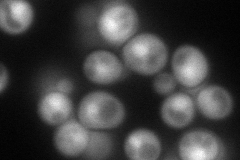
YDR079C-A
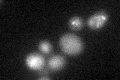
YDR079C-A

View description
Component of the RNA polymerase II general transcription and DNA repair factor TFIIH; involved in transcription initiation and in nucleotide-excision repair; homolog of Chlamydomonas reinhardtii REX1-S protein involved in DNA repair
Localization:
Intensity:
Fold change:
Significance:
-
C’ GFP library in SD

nucleus22.61 -
N' NOP1pr-GFP in SD
cytosol,nucleus115.054 -
N' TEF2pr-mCherry in SD

cytosol,nucleus24.4553 -
N' NATIVEpr-GFP in SD

below threshold24.7317 -
N' TEF2pr-VC and Cyto-VN in SD

#N/A0 -
C’ GFP library in SD+DTT
nucleus19.780.87No -
C’ GFP library in SD+H2O2

punctateN/AN/ANo -
C’ GFP library in Starvation Media

nucleus18.870.83No -
C’ GFP library on the background of Pup2-DaMP

nucleus -
C’ GFP library on the background of CCT mutant

nucleus17.01570.752161No
